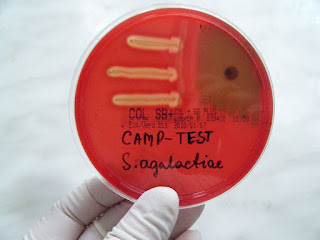

Zakażenie układu moczowego (ZUM) w ciąży może być groźne dla kobiet ciężarnych, a w konsekwencji także może być groźną przyczyną tzw. wczesnego zakażenia w pierwszym tygodniu życia dziecka, wywołując zapalenie dróg moczowych, wsierdzia, układu oddechowego, zapalenie płuc, zapalenie opon mózgowych, a nawet posocznicę.
Zakażenia układu moczowego (ZUM) w ciąży, zarówno dolnego, jak i górnego jego odcinka, stanowią poważny problem kliniczny. Głównym patogenem ZUM w ciąży są bakterie z grupy Enterobacteriaceae, w tym Escherichia coli odpowiedzialna za 63–85% infekcji. Rzadziej spotyka się zakażenia wywołane przez Klebsiella pneumoniae (ok. 8%), gronkowce (Staphylococcus > 15%, w tym S. aureus > 8%) i paciorkowce z grupy B (do 10%). Należy wspomnieć również o drożdżakach.
W przypadku paciorkowców z grupy B: patogenem powodującym groźne w skutkach zakażenia noworodków jest β-hemolizujący paciorkowiec Streptococcus agalactiae, skrótowo nazywanym GBS. GBS występują jako flora komensalna w przewodzie pokarmowym oraz układzie moczowo-płciowym osób dorosłych, a u ok. 10-30% zdrowych kobiet w pochwie nie manifestując żadnych objawów stanu zapalnego.
Ze względu na łatwość przemieszczania się bakterii drogą wstępującą do górnych pięter układu moczowego, wywołaną fizjologicznymi zmianami anatomiczno-czynnościowymi w ciąży, podstawową zasadą w zapobieganiu ZUM jest wczesne rozpoznawanie i leczenie bezobjawowej bakteriurii.
Dla zwiększenia wykrywalności bakteriurii bezobjawowej wykonuje się rutynowe posiewy moczu pomiędzy 12. a 16. tygodniem ciąży lub przy pierwszej wizycie prenatalnej, a w przypadku stwierdzenia wyniku dodatniego – także rutynowo jeden raz w miesiącu do końca ciąży.
Leczenie ZUM w ciąży wymaga ostrożności i znajomości działania leków na płód, gdyż część z nich zagraża jego bezpieczeństwu.
Nie można stosować antybiotyków, jak to się często zdarza jedynie na podstawie wyników ogólnego badania moczu. Nie znamy czynnika etiologicznego, ani czy bakteriuria jest znamienna czy nieznamienna, a to ma istotne znaczenie w interpretacji wyników. Bakteriomocz poniżej 1000 komórek/1ml (103CFU/ml) uważa się za bakteriurię nieznamienną. Wyjątkiem są wyhodowane w moczu pałeczki ropy błękitnej Pseudomonas aeruginosa, których obecność niezależnie od liczby bakterii, świadczy o ZUM. W próbkach moczu obecne mogą być więcej niż dwa różne typy bakterii, których w badaniu ogólnym nie można rozróżnić, wynik świadczy, że prawdopodobnie materiał jest zanieczyszczony, nieprawidłowo pobrany, wobec czego należy badanie powtórzyć. A nie leczyć w ciemno!
Nie ma też możliwości wykonania testu Goulda, by sprawdzić i określić czy w badanej próbce moczu znajdują się czynniki zahamowania wzrostu dla bakterii Gram (+) i Gram (-). Ma to istotne znaczenie dla prawidłowej interpretacji wyniku, gdy wynik jest ujemny lub wątpliwy. To samo dotyczy posiewów na uricultach. Również Testy paskowe stosowane do badań przesiewowych nie są wystarczająco czułe, aby wykryć bakteriurię mniejszą niż 105 komórek w 1 ml moczu.
Błędem lekarskim jest również nie poinformowanie pacjentki o prawidłowym sposobie pobrania próbki moczu, zarówno do badań ogólnych, jak i posiewów bakteriologicznych (sterylny pojemnik, pierwszy poranny mocz, środkowy strumień, prawidłowe podmycie się, szybkie dostarczenie próbki do laboratorium).
Dr n. med. Monika Wieliczko, dr n. med. Mariusz Mieczkowski
Katedra i Klinika Nefrologii, Dializoterapii i Chorób Wewnętrznych WUM
Kierownik Kliniki:
prof. dr hab. n. med. Joanna Matuszkiewicz-Rowińska
Dla zwiększenia wykrywalności bakteriurii bezobjawowej wykonuje się rutynowe posiewy moczu pomiędzy 12. a 16. tygodniem ciąży lub przy pierwszej wizycie prenatalnej, a w przypadku stwierdzenia wyniku dodatniego – także rutynowo jeden raz w miesiącu do końca ciąży.
Leczenie ZUM w ciąży wymaga ostrożności i znajomości działania leków na płód, gdyż część z nich zagraża jego bezpieczeństwu.
Nie można stosować antybiotyków, jak to się często zdarza jedynie na podstawie wyników ogólnego badania moczu. Nie znamy czynnika etiologicznego, ani czy bakteriuria jest znamienna czy nieznamienna, a to ma istotne znaczenie w interpretacji wyników. Bakteriomocz poniżej 1000 komórek/1ml (103CFU/ml) uważa się za bakteriurię nieznamienną. Wyjątkiem są wyhodowane w moczu pałeczki ropy błękitnej Pseudomonas aeruginosa, których obecność niezależnie od liczby bakterii, świadczy o ZUM. W próbkach moczu obecne mogą być więcej niż dwa różne typy bakterii, których w badaniu ogólnym nie można rozróżnić, wynik świadczy, że prawdopodobnie materiał jest zanieczyszczony, nieprawidłowo pobrany, wobec czego należy badanie powtórzyć. A nie leczyć w ciemno!
Nie ma też możliwości wykonania testu Goulda, by sprawdzić i określić czy w badanej próbce moczu znajdują się czynniki zahamowania wzrostu dla bakterii Gram (+) i Gram (-). Ma to istotne znaczenie dla prawidłowej interpretacji wyniku, gdy wynik jest ujemny lub wątpliwy. To samo dotyczy posiewów na uricultach. Również Testy paskowe stosowane do badań przesiewowych nie są wystarczająco czułe, aby wykryć bakteriurię mniejszą niż 105 komórek w 1 ml moczu.
Błędem lekarskim jest również nie poinformowanie pacjentki o prawidłowym sposobie pobrania próbki moczu, zarówno do badań ogólnych, jak i posiewów bakteriologicznych (sterylny pojemnik, pierwszy poranny mocz, środkowy strumień, prawidłowe podmycie się, szybkie dostarczenie próbki do laboratorium).
Zalecenia dotyczące rozpoznawania, leczenia i kontroli bakteryjnej kobiet w ciąży zostały opracowane przez Infectious Diseases Society of America (IDSA) i opublikowane w 2005 r., a dotyczące bezobjawowej bakteriurii także przez US Preventive Services Task Force w 2008.
Dobór leku przeciwbakteryjnego w leczeniu ZUM u ciężarnej jest więc uzależniony od: bezpieczeństwa jego stosowania, okresu ciąży, wyniku posiewu moczu, ciężkości zakażenia i wydolności nerek.
Dobór leku przeciwbakteryjnego w leczeniu ZUM u ciężarnej jest więc uzależniony od: bezpieczeństwa jego stosowania, okresu ciąży, wyniku posiewu moczu, ciężkości zakażenia i wydolności nerek.
Podsumowanie
Wszystkie ZUM (bezobjawowe i objawowe) występujące u kobiet w ciąży wymagają leczenia przeciwbakteryjnego. Leczenie należy prowadzić zgodnie z antybiogramem.
Wszystkie ZUM (bezobjawowe i objawowe) występujące u kobiet w ciąży wymagają leczenia przeciwbakteryjnego. Leczenie należy prowadzić zgodnie z antybiogramem.
Źródło:
Zakażenia układu moczowego (ZUM) w ciąży. 2015-05-18Dr n. med. Monika Wieliczko, dr n. med. Mariusz Mieczkowski
Katedra i Klinika Nefrologii, Dializoterapii i Chorób Wewnętrznych WUM
Kierownik Kliniki:
prof. dr hab. n. med. Joanna Matuszkiewicz-Rowińska